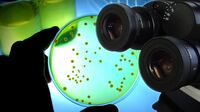
生命は存在せず｢幻想｣であるという奇妙な考え　既知の物理学はなぜ｢生命｣を説明できないのか

コンテンツブロックが有効であることを検知しました。
このサイトを利用するには、コンテンツブロック機能(広告ブロック機能を持つ拡張機能等)を無効にしてページを再読み込みしてください。
なお、Microsoft Edgeをご利用のお客様はプライバシー設定が影響している可能性があるため「追跡防止を有効にする」の設定を「バランス(推奨)」にしてご利用をお願いいたします。詳細は下記のFAQページをご参照ください。
https://help.toyokeizai.net/hc/ja/articles/33846290888345